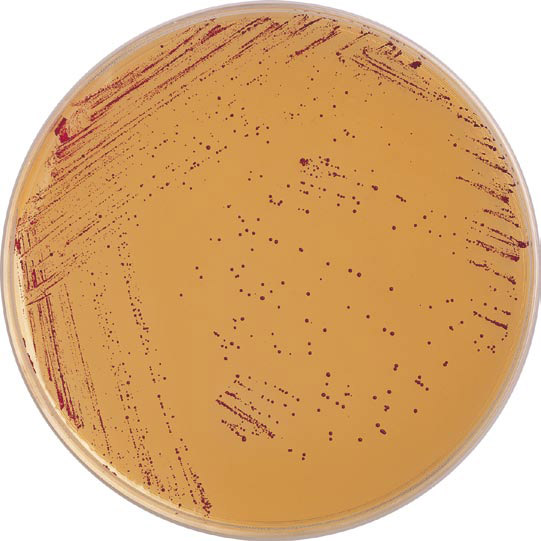
七叶苷培养基价格

产品分类
- 实验抗体 (5736)
- ATCC细胞 (1063)
- elisa定量检测试剂盒 (2839)
- RNA/DNA提取 (1056)
- 标准品 (612)
- Sigma试剂 (2857)
- 培养基 (1337)
- 酶联免疫分析试剂盒 (3135)
- ELISA检测试剂盒 (862)
- 生物抗体 (956)
- PCR试剂盒 (1522)
- DRG试剂盒 (764)
- 原代细胞 (272)
- 标准物质 (1207)
- 生化检测试剂盒 (830)
- 生化试剂 (1006)
- 生化试剂类 (785)
- 细胞生物学 (2249)
- 抗体 (20139)
- 进口品牌 (219)
- 生物碱 (489)
- 黄酮 (535)
- 查尔酮 (51)
- 氧杂蒽酮 (26)
- 木脂素 (214)
- 香豆素 (124)
- 苯丙素 (51)
- 药物杂质及中间体 (829)
- 其它天然产物 (137)
- 蒽醌 (24)
- 其它醌类 (39)
- 甾体 (133)
- 二萜 (417)
- 其它萜类 (50)
- 环烯醚萜 (91)
- 倍半萜 (356)
- 其它酚类 (494)
- 三萜 (432)
- 中药对照品系列 (1330)
- 精细化学 (548)
- 进口试剂盒 (2135)
- 细胞生物学 (740)
- 鉴定试剂盒 (923)
- 细胞库 (661)
- 培养基/实验耗材 (1253)
- 感受态菌株 (2073)
- 蛋白与免疫 (5971)
- 耗材和仪器 (1)
- 分子生物学 (512)
- 抗体 (3338)
- 细胞系 (554)
- LAMP试剂盒 (1504)
- 荧光定量PCR试剂盒 (1123)
- 标准溶液 (1343)
- ELISA Kit (2831)
- ELISA检测试剂盒 (3492)
- 进口PCR试剂 (4902)
- 进口ELISA试剂盒 (4996)
- 蛋白 (2506)
- 其他分类 (14)